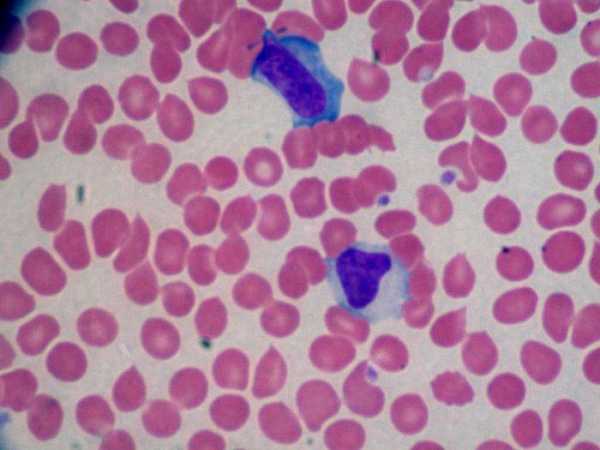

Инфекционный мононуклеоз | Компетентно о здоровье на iLive
Какие симптомы имеет инфекционный мононуклеоз?
У большинства молодых людей первичная Эпштейн-Барр инфекция протекает асимптоматично. Симптомы инфекционного мононуклеоза более часто развиваются у детей старшего возраста и взрослых.
Инкубационный период инфекционного мононуклеоза составляет 30-50 дней. Обычно сначала развивается слабость, на протяжении нескольких дней, недели или больше, затем появляются лихорадка, фарингит и лимфаденопатия. Не обязательно встречаются все эти симптомы. Слабость и утомляемость могут длиться месяцами, но наиболее выраженны в первые 2-3 недели. Лихорадка имеет пик в обеденное время или ранним вечером, с максимальным подъемом температуры до 39,5 «С, иногда достигая 40,5 «С. Когда в клинической картине преобладают слабость и лихорадка (так называемая тифоподобная форма), обострение и разрешение происходят более медленно. Фарингит может быть тяжелым, сопровождаться болью, экссудацией и осложняться стрептококковой инфекцией. Характерно развитие аденопатии передних и задних шейных лимфоузлов; аденопатия симметрична. Иногда увеличение лимфоузлов является единственным проявлением болезни.
Приблизительно в 50 % случаев имеет место спленомегалия с максимальным увеличением селезенки в течение 2-й и 3-й недель болезни, причем обычно пальпируется ее край. Выявляются умеренное увеличение печени и ее чувствительность при перкуссии или пальпации. Менее часто выявляются пятнисто-папулезная сыпь, желтуха, периорбитальный отек, энантема твердого неба.
Осложнения инфекционного мононуклеоза
Несмотря на то что обычно больные выздоравливают, оcложнения инфекционного мононуклеоза могут носить драматический характер.
Среди неврологических осложнений следует инфекционного мононуклеоза помнить об энцефалите, судорогах, синдроме Гийена-Барре, периферической нейропатии, асептическом менингите, миелите, параличе черепных нервов и психозе. Энцефалит может проявляться мозжечковыми нарушениями либо иметь более серьезное и прогрессирующее течение, подобно герпетическим энцефалитам, но со склонностью к саморазрешению.
Гематологические нарушения обычно проходят сами. Могут обнаруживаться гранулоцитопения, тромбоцитопения и гемолитическая анемия. Преходящая, умеренно выраженная гранулоцитопения или тромбоцитопения имеет место приблизительно у 50 %больных; присоединение бактериальной инфекции или кровотечение наблюдаются менее часто. Гемолитическая анемия развивается в результате появления античспецифических аутоантител.
Разрыв селезенки может быть одним из серьезнейших последствий инфекционного мононуклеоза. Он происходит в результате значительного увеличения ее размеров и отека капсулы (максимально — на 10-21-й день заболевания), причем травма имеет место приблизительно у половины больных. Разрыв селезенки сопровождается болью, но иногда проявляется в виде безболезненной гипотензии.
Редкие респираторные осложнения инфекционного мононуклеоза включают обструкцию верхних дыхательных путей в результате аденопатии гортанных и околотрахеальных лимфоузлов; эти осложнения поддаются кортикостероидной терапии. Клинически бессимптомные интерстициальные легочные инфильтраты встречаются обычно у детей и хорошо выявляются при рентгенологическом исследовании.
Печеночные осложнения встречаются у около 95 % больных и включают повышение аминотрансфераз (2-3-кратное превышение нормы и возврат к исходному уровню спустя 3-4 недели). Если развивается желтуха и более значительное повышение активности печеночных ферментов, следует исключить другие причины поражения печени.
Генерализованная инфекция ЭБВ иногда имеет место, но охватывает семьи, особенно с Х-связанным лимфопролиферативным синдромом. Эти лица, перенесшие ЭБВ-инфекцию, имеют повышенный риск развития агаммаглобулинемии или лимфомы.
[1], [2], [3], [4], [5], [6], [7], [8], [9], [10], [11], [12], [13], [14], [15], [16]
ilive.com.ua
Мононуклеоз: симптомы, лечение, осложнения
Мононуклеозом называют острую инфекцию вирусного происхождения, поражающую ретикуло-эндотелиальную систему, что приводит к множественному увеличению лимфоузлов, вовлечению в процесс печени и селезенки, а также к изменениям в системе крови.
Это ведет к снижению иммунитета и развитию типичной клинической картины болезни, токсикоза и ангины.
Причины
На сегодня точно известно то, что данное заболевание вызывается вирусом Эббштейн-Барр – это вирус, поражающий преимущественно лимфоцитарное звено иммунной системы, относится к группе герпесных вирусов, 4 типа. Вирус относят к ДНК-содержащим, кроме мононуклеоза может вызвать лимфомы Беркитта, карциномы и лимфомы у иммунодефицитных пациентов.
У детей попадание вируса вызывает инфекционный мононуклеоз, а затем вирус длительно, иногда пожизненно, циркулирует в организме, находясь в состоянии латентного инфицирования.
Источник инфицирования – больной ребенок в типичной или стертой форме, хотя заболевание является слабо заразным и нужен длительный и тесный контакт, поцелуи, переливание компонентов крови, пользование общей посудой.
Носители вируса могут выделять его при первичном инфицировании до полутора лет, а в дальнейшем могут возникать бессимптомные периоды вирусо-выделения.
Большая часть детей и взрослых переносит мононуклеоз в стертой форме, типичные формы в основном бывают у часто или длительно болеющих детей от 5 до 14 лет.
Классификация
На сегодня нет единого способа классификации мононуклеоза. Сегодня выделяют типичные и атипичные формы, которые имеют клинику, отличающуюся от традиционной.
Также выделяют острый (возникающий остро ярко, проходящий за несколько недель) и хронический мононуклеоз (длящийся до полугода процесс).
Отдельно выделяется инфицирование вирусом Эббштейн-Барр при иммунодефицитных состояниях и ВИЧ.
Проявления мононуклеоза
Период инкубации при мононуклеозе может длиться от нескольких суток до 2 недель, обычно неделю.
- Болезнь начинается с высокой лихорадки, достигающей 38-40°C, резко возникающей на фоне полного здоровья.
- На 2-3 сутки лихорадка с симптомами токсикоза достигают максимума, возникают сильная слабость и головные боли, боли в мышцах и суставах, потом присоединяются сильные боли в горле при глотании и в покое.
- Температура колеблется в течение дня, не имея определенных закономерностей, плохо поддается жаропонижающей терапии, в среднем лихорадка длится около недели, постепенно идя на убыль.
Основной симптом мононуклеоза – типичный тонзиллит, ангина на фоне лихорадки и токсикоза. Ангина может иметь катаральный или лакунарный характер (т.е. быть гнойной или нет), реже — пленчатый или некротический, особенно сильная ангина возникает при снижении в крови гранулоцитов. Характерны сильные боли в горле при глотании, может быть сильное першение, зуд и сухость в горле.
Еще одно из типичных проявлний – увеличение лимфоузлов в области челюсти и шеи, подмышечных и паховых лимфоузлов. Могут также проявляться поражения внутригрудных и мезентериальных лимфоузлов, что дает кашель и сильные боли в животе.
Примерно у половины больных при мононуклеозе на теле возникает сыпь, которая носит различный характер в зависимости от дня заболевания – в 3-5 сутки болезни она может иметь кореподобную картину, может быть в виде розеол, папул или мелких кровоизлияний. Сыпь может держаться на коже 1-3 суток и бесследно исчезает без пигментации и шелушения. Новой сыпи дополнительно не появляется.
На фоне течения мононуклеоза у детей резко увеличивается размер печени и селезенки, они выявляются с 3-5 суток болезни и могут находиться в таком состоянии до 4 недель. Особенно тяжело протекают желтушные формы с поражением ткани печени и увеличением количества билирубина, уровня ферментов печени, особенно щелочной фосфатазы.
Типичны изменения в анализе периферической крови детей при мононуклеозе – возникает не резко выраженный лейкоцитоз до 10*10 9/л лейкоцитов, при этом резко увеличено количество лимфоцитов и моноцитов, в крови выявляют специфические клетки – атипичные мононуклеары, которые и подтверждают диагноз.
Изменения крови держатся более всего, дисбаланс лейкоцитов и лимфоцитов может сохраняться до полугода. На фоне мононуклеоза происходит снижение иммунитета, что приводит к повышенной заболеваемости респираторными инфекциями.
Диагностика
Основа диагноза – клиническая картина болезни с типичными проявлениями, описанными ранее. Особенно большое значение для диагностики играет исследование крови с выявлением атипичных мононуклеаров в комбинации с повышением лимфоцитов и понижением лейкоцитов.
Сегодня самыми популярными являются определение антител к вирусу Эббштейн-Барр класса IgM (антитела свежей инфекции) и класса IgG, которые подтверждают инфекцию пост-фактум.
Необходимо отличать мононуклеоз от банальной ангины, дифтерии и цитомегаловирусного поражения, ВИЧ-инфекции, гепатитов при поражении печени и кори, краснухи и других детских инфекций при сыпи.
Лечение мононуклеоза
Лечением мононуклеоза занимаются врачи-педиатры и инфекционисты.
Специфической терапии против вируса Эббштейн-Барр не разработано, поэтому применяется неспецифическая терапия противовирусными препаратами и иммуномодуляторами (арбидол, виферон, ацикловир, имудон).
В основном лечение направлено на борьбу с симптомами заболевания – применение местных антисептиков и обезболивающих при ангине (биопарокс, гексорал, фарингосепт), жаропонижающие (парацетамол, нурофен).
Пристальное внимание уделяют восстановлению печени.
При опасности осложнений зачастую применяют антибиотики с целью предотвращения вторичного инфицирования на фоне сниженного иммунитета. В основном лечение проводят на дому, в редких случаях тяжелого течения проводится стационарное лечение.
Осложнения
Мононуклеоз опасен своими осложнениями в виде гемолитической анемии. Самым опасным осложнением является спонтанный разрыв селезенки вследствие ее резкого увеличения. У детей также нередки поражения дыхательных путей с обструкцией бронхов и возникновение пневмонии.
Прогноз и профилактика
При мононуклеозе прогнозы благоприятные, но после перенесенной инфекции длительно остается снижение иммунитета, которое приводит к усилению заболеваемости простудными заболеваниями. Снижение иммунитета длится до полугода.
Специфической вакцины и медикаментов для профилактики мононуклеоза не разработано, проводятся профилактические мероприятия общего плана – закаливание, прием поливитаминов, промывание слизистых носа и горла.
www.diagnos.ru
Мононуклеоз: что за болезнь?
Мононуклеоз относится к инфекции вирусного типа, которая поражает систему макрофагов, вследствие чего происходит нарушение на клеточном уровне.
В ходе диагностики можно заметить увеличение лимфатических узлов, патологические изменения со стороны печени, селезенки, кроветворной системы.
В ходе заболевания снижается иммунитет, появляется токсикоз, ангина. В данной статье рассмотри причины заболевания и ответим на вопрос: «Что за болезнь мононуклеоз?».
Мононуклеоз: причины развития
Основная причина развития заболевания вирус Эпштейна-Барра, относится к герпесной группе, поражает лимфоциты — звено иммунной системы. Если вирус попадает в организм детей, то заболевание диагностирует как инфекционный мононуклеоз.
Источником инфекции является больной, носитель вируса. Однако для заражения нужен длительный контакт (проживание в одном помещении, совместное использование предметов быта).
Заболевание мононуклеоз и его классификация
В медицинской практике на сегодня нет четкой классификации болезни. Однако выделяют острую форму, когда симптоматика ярко выраженная и нередко требуется госпитализация, а также хроническую — болезнь протекает вяло в течение 6-8 месяцев.
Мононуклеоз: симптомы инфекции
Период инкубации при данном заболевании может длиться от 48 часов до 14 дней. Основное проявление мононуклеоза следующее:
- резкое повышение температуры тела (до 39-40°C), которая не снижается даже после жаропонижающих средств;
- через несколько дней после повышения температуры возникает тошнота, рвота, больного лихорадит;
- головная боль, слабость, ломота в теле, признаки ангины.
К основному симптому мононуклеоза все же относят развитие ангины, которая сопровождается рвотой и высокой температурой. Возникает сильная боль в горле, при этом, ангина может нести гнойный характер.
Еще один характерный симптом — высыпания по телу больного, которые не всегда имеют стандартный вид. Обычно, сыпь держится недолго, не более 3 дней.
У детей, которые перенесли инфекционный мононуклеоз, как симптомы, могут наблюдаться незначительные увеличения селезенки и печени. Но если лечение было своевременным и качественным, то после терапии через 4-6 недель органы приходят в норму.
Мононуклеоз: методы диагностирования
Предположить диагноз мононуклеоз можно уже по описанию клинической картины. Но развернутый анализ крови все же играет решающую роль в подтверждении заболевания.
Основное исследование крови будет направлено на обнаружение вируса Эпштейна-Барра, а также антител. Данное исследование является важным, так как нужно четко отличать мононуклеоз от ангины, гепатита, кори или ВИЧ-инфекции.
Принципы лечения заболевания
Мононуклеоз лечится исключительно под присмотром врачей – педиатра или терапевта, а также инфекциониста. Конкретного метода для уничтожения вируса Эпштейна-Барра на сегодня не существует. По этой причине терапия заключается в применении противовирусных препаратов и средств моделирующих иммунную систему. В случае развития тонзиллита, лакунарной ангины, необходимо назначение антибиотиков, преимущественно цефалоспоринового ряда, к примеру: цефазолин, цефтриаксон. При аллергии на пенициллины препаратами выбора являются макролиды: азитромицин, мидекамицин, кларитромицин. Они относятся к наименее токсичным средствам. Их проще применять в детской практике.
Также лечение будет направлено на уменьшение и устранение симптомов. Для этих целей могут применяться препараты местного действия, например, хлорофиллипт, стоматидин, Биопарокс или Гексорал. Препараты помогут снять воспаление и боли в горле. Дополнительно назначаются жаропонижающие средства — Нурофен, Ибупрофен.
Поскольку заболевание дает наибольшее осложнение на печень, то после лечения рекомендуется пройти курс терапии гепатопротекторами — Эссенциале форте, Карсил, Галстена. Лечение возможно проводить дома, но если речь идет о маленьких детях, то врачи рекомендует все же госпитализацию.
Возможные осложнения
Мононуклеоз опасная инфекция и в ряде случаев может давать серьезные последствия — от развития гепатита до разрыва селезенки. Также может возникать сильное поражение дыхательных путей (воспалительного характера) до возникновения дыхательной недостаточности. У детей осложнения после мононуклеоза характеризуются развитием пневмонии.
Какой прогноз при мононуклеозе?
Своевременное и правильное лечение заболевания дает весьма положительный прогноз. Однако инфекция слишком негативно влияет на иммунную систему, что в дальнейшем провоцирует частые простудные заболевания. Поэтому, периодически курс иммуностимулирующих средств придется проходить. Также в будущем увеличивается риск возникновения частых ангин или тонзиллита.
На сегодня вакцины от вируса, который провоцирует мононуклеоз, нет. По этой причине профилактические меры заключаются в поддержании своего здоровья: закаливание, спорт, прием витаминов, промывание слизистой носа, бережное отношение к состоянию дыхательной системы. При малейших подозрениях на данную инфекцию требуется в срочном порядке обратиться к врачу, а лучше вызвать на дом.
antirodinka.ru
Инфекционный мононуклеоз — симптомы болезни, профилактика и лечение Инфекционного мононуклеоза, причины заболевания и его диагностика на EUROLAB
Что такое Инфекционный мононуклеоз —
Инфекционный мононуклеоз (mononucleosis infectiosa, болезнь Филатова, ангина моноцитарная, лимфобластоз доброкачественный) — острое антропонозное вирусное инфекционное заболевание с лихорадкой, поражением ротоглотки, лимфатических узлов, печени и селезёнки и специфическими изменениями гемограммы.Клинические проявления заболевания впервые описаны Н.Ф. Филатовым («болезнь Филатова», 1885) и Е. Пфайффером (1889). Изменения гемограммы изучены многими исследователями (Берне Й., 1909; Тайди Г. с соавт., 1923; Шварц Е., 1929, и др.). В соответствии с этими характерными изменениями американские учёные Т. Спрэнт и Ф. Эванс назвали заболевание инфекционным мононуклеозом. Возбудитель впервые выделили английский патолог М.А. Эпстайн и канадский вирусолог И. Барр из клеток лимфомы Бёркитта (1964). Позднее вирус получил название вируса Эпстайна-Барр.
Что провоцирует / Причины Инфекционного мононуклеоза:
Возбудитель инфекционного мононуклеоза— ДНК-геномный вирус рода Lymphocryptovirus подсемейства Gammaherpesvirinae семейства Herpesviridae. Вирус способен реплицироваться, в том числе в В-лимфоцитах; в отличие от других вирусов герпеса он не вызывает гибели клеток, а напротив, активирует их пролиферацию. Вирионы включают специфические антигены: капсидный (VCA), ядерный (EBNA), ранний (ЕА) и мембранный (МА) антигены. Каждый из них образуется в определённой последовательности и индуцирует синтез соответствующих антител. В крови больных инфекционным мононуклеозом сначала появляются антитела к капсидному антигену, позднее вырабатываются антитела к ЕА и МА. Возбудитель малоустойчив во внешней среде и быстро гибнет при высыхании, под действием высокой температуры и дезинфектантов.Инфекционный мононуклеоз — только одна из форм инфекции вирусом Эпстайна-Барр, который также вызывает лимфому Бёркитта и носоглоточную карциному. Его роль в патогенезе ряда других патологических состояний недостаточно изучена.
Резервуар и источник инфекции — человек с манифестной или стёртой формой болезни, а также носитель возбудителя. Инфицированные лица выделяют вирус с последних дней инкубации и на протяжении 6-18 мес после первичной инфекции. В смывах из ротоглотки у 15-25% серопозитивных здоровых людей также обнаруживают вирус. Эпидемический процесс поддерживают лица, ранее перенёсшие инфекцию и на протяжении долгого времени выделяющие возбудитель со слюной.
Механизм передачи — аэрозольный, путь передачи — воздушно-капельный. Очень часто вирус выделяется со слюной, поэтому возможно заражение контактным путём (при поцелуях, половым путём, через руки, игрушки и предметы обихода). Возможна передача инфекции при переливаниях крови, а также во время родов.
Естественная восприимчивость людей высокая, однако, преобладают лёгкие и стёртые формы болезни. О наличии врождённого пассивного иммунитета может свидетельствовать крайне низкая заболеваемость детей первого года жизни. Иммунодефицитные состояния способствуют генерализации инфекции.
Основные эпидемиологические признаки. Заболевание распространено повсеместно; в основном регистрируют спорадические случаи, иногда — небольшие вспышки. Полиморфность клинической картины, довольно частые сложности диагностики болезни дают основания полагать, что уровень официально регистрируемой заболеваемости в Украине не отражает истинной широты распространения инфекции. Наиболее часто заболевают подростки, у девочек максимальную заболеваемость регистрируют в 14-16 лет, у мальчиков — в 16-18 лет. Поэтому иногда инфекционный мононуклеоз также называют болезнью «студентов». Лица старше 40 лет болеют редко, но у ВИЧ-инфицированных реактивация латентной инфекции возможна в любом возрасте. При заражении в раннем детском возрасте первичная инфекция протекает в виде респираторного заболевания, в более старших возрастах — бессимптомно. К 30-35 годам у большинства людей в крови выявляют антитела к вирусу инфекционного мононуклеоза, поэтому клинически выраженные формы редко встречают среди взрослых. Заболевания регистрируют на протяжении всего года, несколько реже — в летние месяцы. Заражению способствуют скученность, пользование общим бельём, посудой, тесные бытовые контакты.
Патогенез (что происходит?) во время Инфекционного мононуклеоза:
Проникновение вируса в верхние отделы дыхательных путей приводит к поражению эпителия и лимфоидной ткани рото- и носоглотки. Отмечают отёк слизистой оболочки, увеличение миндалин и регионарных лимфатических узлов. При последующей вирусемии возбудитель внедряется в В-лимфоциты; находясь в их цитоплазме, он диссеминирует по всему организму. Распространение вируса приводит к системной гиперплазии лимфоидной и ретикулярной тканей, в связи с чем в периферической крови появляются атипичные мононуклеары. Развиваются лимфаденопатия, отёк слизистой оболочки носовых раковин и ротоглотки, увеличиваются печень и селезёнка. Гистологически выявляют гиперплазию лимфоретикулярной ткани во всех органах, лимфоцитарную перипортальную инфильтрацию печени с незначительными дистрофическими изменениями гепатоцитов.Репликация вируса в В-лимфоцитах стимулирует их активную пролиферацию и дифференцировку в плазмоциты. Последние секретируют иммуноглобулины низкой специфичности. Одновременно в острый период заболевания нарастают количество и активность Т-лимфоцитов. Т-супрессоры сдерживают пролиферацию и дифференцировку В-лимфоцитов. Цитотоксические Т-лимфоциты уничтожают инфицированные вирусом клетки, распознавая мембранные вирус-индуцированные антигены. Однако вирус остаётся в организме и персистирует в нём в течение всей последующей жизни, обусловливая хроническое течение заболевания с реактивацией инфекции при снижении иммунитета.
Выраженность иммунологических реакций при инфекционном мононуклеозе позволяет считать его болезнью иммунной системы, поэтому его относят к группе заболеваний СПИД-ассоциированного комплекса.
Симптомы Инфекционного мононуклеоза:
Инкубационный период варьирует от 5 дней до 1,5 мес. Возможен продромальный период, не имеющий специфической симптоматики. В этих случаях заболевание развивается постепенно: в течение нескольких дней наблюдают субфебрильную температуру тела, недомогание, слабость, повышенную утомляемость, катаральные явления в верхних дыхательных путях — заложенность носа, гиперемию слизистой оболочки ротоглотки, увеличение и гиперемию миндалин.При остром начале заболевания температура тела быстро поднимается до высоких цифр. Больные жалуются на головную боль, боли в горле при глотании, озноб, усиленное потоотделение, ломоту в теле. В дальнейшем температурная кривая может быть различной; длительность лихорадки варьирует от нескольких дней до 1 мес и более.
К концу первой недели заболевания развивается период разгара болезни. Характерно появление всех основных клинических синдромов: общетоксических явлений, ангины, лимфаденопатии, гепатолиенального синдрома. Самочувствие больного ухудшается, отмечают высокую температуру тела, озноб, головную боль и ломоту в теле. Могут появиться заложенность носа с затруднением носового дыхания, гнусавость голоса. Поражения зева проявляются нарастанием боли в горле, развитием ангины в катаральной, язвенно-некротической, фолликулярной или плёнчатой форме. Гиперемия слизистой оболочки выражена нерезко, на миндалинах появляются рыхлые желтоватые легко снимающиеся налёты. В некоторых случаях налёты могут напоминать дифтерийные. На слизистой оболочке мягкого нёба возможно появление геморрагических элементов, задняя стенка глотки резко гиперемированная, разрыхлённая, зернистая, с гиперплазированными фолликулами.
С первых же дней развивается лимфаденопатия. Увеличенные лимфатические узлы можно обнаружить во всех доступных пальпации областях; характерна симметричность их поражения. Наиболее часто при мононуклеозе увеличиваются затылочные, подчелюстные и особенно заднешейные лимфатические узлы с обеих сторон по ходу грудино-ключично-сосцевидных мышц. Лимфатические узлы уплотнены, подвижны, при пальпации безболезненны или болезненны незначительно. Их размеры варьируют от горошины до грецкого ореха. Подкожная клетчатка вокруг лимфатических узлов в некоторых случаях может быть отёчной.
У большинства больных в период разгара заболевания отмечают увеличение печени и селезёнки. В некоторых случаях развивается желтушный синдром: усиливаются диспептические явления (снижение аппетита, тошнота), темнеет моча, появляется иктеричность склер и кожи, в сыворотке крови нарастает содержание билирубина и повышается активность аминотрансфераз.
Иногда появляется экзантема пятнисто-папулёзного характера. Она не имеет определённой локализации, не сопровождается зудом и быстро исчезает без лечения, не оставляя изменений на коже.
Вслед за периодом разгара заболевания, продолжающимся в среднем 2-3 нед, наступает период реконвалесценции. Самочувствие больного улучшается, нормализуется температура тела, постепенно исчезают ангина и гепатолиенальный синдром. В дальнейшем нормализуются размеры лимфатических узлов. Длительность периода реконвалесценции индивидуальна, иногда субфебрильная температура тела и лимфаденопатия сохраняются в течение нескольких недель.
Заболевание может протекать длительно, со сменой периодов обострений и ремиссий, из-за чего его общая продолжительность может затягиваться до 1,5 лет.
Клинические проявления инфекционного мононуклеоза у взрослых больных отличаются рядом особенностей. Заболевание часто начинается с постепенного развития продромальных явлений, лихорадка часто сохранятся более 2 нед, выраженность лимфаденопатии и гиперплазии миндалин меньше, чем у детей. Вместе с тем у взрослых чаще наблюдают проявления заболевания, связанные с вовлечением в процесс печени и развитием желтушного синдрома.
Осложнения инфекционного мононуклеоза
Наиболее частое осложнение — присоединение бактериальных инфекций, вызванных золотистым стафилококком, стрептококками и др. Также возможны менингоэнцефалит, обструкция верхних отделов респираторного тракта увеличенными миндалинами. В редких случаях отмечают двустороннюю интерстициальную инфильтрацию лёгких с тяжёлой гипоксией, тяжёлый гепатит (у детей), тромбоцитопению, разрывы селезёнки. В большинстве случаев прогноз заболевания благоприятный.
Диагностика Инфекционного мононуклеоза:
Инфекционный мононуклеоз следует отличать от лимфогранулематоза и лимфолейкоза, ангин кокковой и иной этиологии, дифтерии ротоглотки, а также вирусных гепатитов, псевдотуберкулёза, краснухи, токсоплазмоза, хламидийных пневмоний и орни-тоза, некоторых форм аденовирусной инфекции, ЦМВ-инфекции, первичных проявлений ВИЧ-инфекции. Инфекционный мононуклеоз отличает сочетание основных пяти клинических синдромов: общетоксических явлений, двусторонней ангины, полиаденопатии (особенно с поражением лимфатических узлов по ходу грудино-ключично-сосцевидных мышц с обеих сторон), гепатолиенального синдрома, специфических изменений гемограммы. В некоторых случаях возможны желтуха и (или) экзантема пятнисто-папулёзного характера.Лабораторная диагностика инфекционного мононуклеоза
Наиболее характерный признак — изменения клеточного состава крови. В гемограмме выявляют умеренный лейкоцитоз, относительную нейтропению со сдвигом лейкоцитарной формулы влево, значительное увеличение количества лимфоцитов и моноцитов (суммарно более 60%). В крови присутствуют атипичные мононуклеары — клетки с широкой базофильной цитоплазмой, имеющие различную форму. Их наличие в крови определило современное название болезни. Диагностическое значение имеет увеличение количества атипичных мононуклеаров с широкой цитоплазмой не менее чем до 10-12%, хотя число этих клеток может достигать 80-90%. Следует заметить, что отсутствие атипичных мононуклеаров при характерных клинических проявлениях заболевания не противоречит предполагаемому диагнозу, поскольку их появление в периферической крови может задерживаться до конца 2-3-й недели болезни.
В период реконвалесценции количество нейтрофилов, лимфоцитов и моноцитов постепенно нормализуется, однако довольно часто длительно сохраняются атипичные мононуклеары.
Вирусологические методы диагностики (выделение вируса из ротоглотки) на практике не применяют. Методом ПЦР можно выявлять вирусную ДНК в цельной крови и сыворотке.
Разработаны серологические методы определения антител различных классов к капсидным (VCA) антигенам. Сывороточные IgM к VCA-антигенам можно обнаружить уже в инкубационный период; в дальнейшем их выявляют у всех больных (это служит достоверным подтверждением диагноза). Исчезают IgM к VCA-антигенам лишь через 2-3 мес после выздоровления. После перенесённого заболевания пожизненно сохраняются IgG к VCA-антигенам.
При отсутствии возможности определения анти-VCA-IgM до сих пор применяют серологические методы обнаружения гетерофильных антител. Они образуются в результате поликлональной активации В-лимфоцитов. Наиболее популярны реакция Пауля-Буннеля с эритроцитами барана (диагностический титр 1:32) и более чувствительная реакция Гоффа-Бауэра с эритроцитами лошади. Недостаточная специфичность реакций снижает их диагностическую ценность.
Всем больным с инфекционным мононуклеозом или при подозрении на него нужно проводить 3-кратное (в острый период, затем через 3 и 6 мес) лабораторное обследование на антител к антигенам ВИЧ, поскольку в стадию первичных проявлений ВИЧ-инфекции также возможен мононуклеозоподобный синдром.
Лечение Инфекционного мононуклеоза:
Больных лёгкими и среднетяжёлыми формами инфекционного мононуклеоза можно лечить на дому. Необходимость постельного режима определяется выраженностью интоксикации. В случаях заболевания с проявлениями гепатита рекомендуют диету (стол №5).Специфическая терапия не разработана. Проводят дезинтоксикационную терапию, десенсибилизирующее, симптоматическое и общеукрепляющее лечение, полоскания ротоглотки растворами антисептиков. Антибиотики при отсутствии бактериальных осложнений не назначают. При гипертоксическом течении заболевания, а также при угрозе асфиксии, обусловленной отёком глотки и выраженным увеличением миндалин, назначают короткий курс лечения глюкокортикоидами (преднизолон внутрь в суточной дозе 1-1,5 мг/кг в течение 3-4 дней).
Профилактика Инфекционного мононуклеоза:
Общие меры профилактики аналогичны таковым при ОРВИ. Меры специфической профилактики не разработаны. Неспецифическую профилактику осуществляют повышением общей и иммунологической резистентности организма.
К каким докторам следует обращаться если у Вас Инфекционный мононуклеоз:
Вас что-то беспокоит? Вы хотите узнать более детальную информацию о Инфекционного мононуклеоза, ее причинах, симптомах, методах лечения и профилактики, ходе течения болезни и соблюдении диеты после нее? Или же Вам необходим осмотр? Вы можете записаться на прием к доктору – клиника Eurolab всегда к Вашим услугам! Лучшие врачи осмотрят Вас, изучат внешние признаки и помогут определить болезнь по симптомам, проконсультируют Вас и окажут необходимую помощь и поставят диагноз. Вы также можете вызвать врача на дом. Клиника Eurolab открыта для Вас круглосуточно.
Как обратиться в клинику:
Телефон нашей клиники в Киеве: (+38 044) 206-20-00 (многоканальный). Секретарь клиники подберет Вам удобный день и час визита к врачу. Наши координаты и схема проезда указаны здесь. Посмотрите детальнее о всех услугах клиники на ее персональной странице.
Если Вами ранее были выполнены какие-либо исследования, обязательно возьмите их результаты на консультацию к врачу. Если исследования выполнены не были, мы сделаем все необходимое в нашей клинике или у наших коллег в других клиниках.
У Вас ? Необходимо очень тщательно подходить к состоянию Вашего здоровья в целом. Люди уделяют недостаточно внимания симптомам заболеваний и не осознают, что эти болезни могут быть жизненно опасными. Есть много болезней, которые по началу никак не проявляют себя в нашем организме, но в итоге оказывается, что, к сожалению, их уже лечить слишком поздно. Каждое заболевание имеет свои определенные признаки, характерные внешние проявления – так называемые симптомы болезни. Определение симптомов – первый шаг в диагностике заболеваний в целом. Для этого просто необходимо по несколько раз в год проходить обследование у врача, чтобы не только предотвратить страшную болезнь, но и поддерживать здоровый дух в теле и организме в целом.
Если Вы хотите задать вопрос врачу – воспользуйтесь разделом онлайн консультации, возможно Вы найдете там ответы на свои вопросы и прочитаете советы по уходу за собой. Если Вас интересуют отзывы о клиниках и врачах – попробуйте найти нужную Вам информацию в разделе Вся медицина. Также зарегистрируйтесь на медицинском портале Eurolab, чтобы быть постоянно в курсе последних новостей и обновлений информации на сайте, которые будут автоматически высылаться Вам на почту.
Другие заболевания из группы Инфекционные и паразитарные болезни:
Если Вас интересуют еще какие-нибудь виды болезней и группы заболеваний человека или у Вас есть какие-либо другие вопросы и предложения – напишите нам, мы обязательно постараемся Вам помочь.www.eurolab-portal.ru
Инфекционный мононуклеоз у детей, у взрослых
Болезнь Филатова, называемая также мононуклеозом, представляет собой острое вирусное заболевание. Оно очень опасно, особенно если возникает у ребенка. Некоторые люди не обращаются вовремя к врачу, думая, что это всего лишь грипп или ангина (симптомы этих заболеваний схожи с признаками мононуклеоза).
Чем раньше будет начато лечение инфекционного мононуклеоза, тем меньше вероятность возникновения различных осложнений.
Что такое мононуклеоз?
Мононуклеоз возникает у человека из-за вируса Эпштейна-Барра. Он относится к семейству герпесвирусов. Данный вирус был открыт в прошлом веке, а именно в 1964 году. Его описали два канадских исследователя, в честь которых вирус и получил название.
Источником инфекции всегда выступает больной человек. Заболеть можно в любое время года. Эпидемии не возникают, так как заразность заболевания невелика. В основном регистрируются лишь отдельные случаи. Возможны локальные вспышки.
Возбудитель передается воздушно-капельным и контактным путем. Например, вирус может попасть в организм со слюной при поцелуе. Также заражение может произойти из-за использования общей посуды, постельного белья, переливания крови. Инфекционный мононуклеоз у детей может возникнуть из-за использования игрушек, которые принадлежат больным малышам.
Вирус Эпштейна-Барра, попадая в верхние дыхательные пути, проникает в слизистую оболочку, лимфатические узлы и начинает размножаться. Вместо B-лимфоцитов организм человека начинает вырабатывать новые клетки, называемые атипичными мононуклеарами.
Мононуклеоз в быту называют «болезнью студентов». Такое название возникло не зря. Это объясняется тем, что заболевание чаще всего встречается у подростков и молодых людей. Мононуклеоз у взрослых практически не встречается. Примерно к 25-30 годам у большинства людей в крови появляются антитела к возбудителю.
Симптомы мононуклеоза
В раннем возрасте у детей заболевание может никак не проявлять себя. Зачастую оно протекает бессимптомно. Признаки заболевания отчетливо наблюдаются лишь у подростков и лиц старшего возраста.
Инкубационный период длится от одной недели до одного месяца. В первое время появляются такие симптомы, как вялость, усталость, разбитость. Затем поднимается температура до 38,0-39,0 градусов. Увеличиваются лимфатические узлы: подчелюстные, затылочные, заднешейные. При надавливании на них чувствуется сильная боль.
У всех больных людей увеличиваются селезенка и печень. Довольно часто кожные покровы приобретают желтый оттенок. Возникает так называемая желтуха. При мононуклеозе тяжелых гепатитов не бывает. Печень в течение продолжительного времени остается увеличенной. Орган принимает нормальные размеры только через 1-2 месяца после момента заражения.
Почти у всех людей, заразившихся мононуклеозом, поражаются миндалины и носоглотка. Возникает заложенность носа, затрудняется носовое дыхание. Голос становится сиплым. Один из симптомов мононуклеоза у детей – это храп во сне.
Возможно появление налета на небных миндалинах. Он может быть в виде «островков» или сплошным. Как правило, при появлении налета температура значительно повышается (до 39,0-39,5 градусов). Самочувствие больного ухудшается. Воспалительные изменения не сопровождаются болями в горле. В некоторых случаях они могут быть несильными. Насморка тоже нет.
Также возможны следующие симптомы:
- бронхит;
- боли в суставах и мышцах;
- головокружения;
- головные боли
Иногда возникают кожные поражения, вызываемые вирусом герпеса, мелкие высыпания на слизистых оболочках рта и кожных покровах. Сыпь на теле походит на обычную аллергическую реакцию. Она пятнистая и ярко-красная. В основном сыпь появляется на теле тех людей, которые проходили курс лечения ампициллином. Высыпания не требуют дополнительного лечения. Через 1-2 недели от них не остается и следа.
Опасен ли инфекционный мононуклеоз?
В большинстве случаев выздоровление наступает через 2-4 недели. Иногда этот процесс затягивается на более длительный период (например, на 1,5 месяца).
Вирус Эпштейна-Барра поражает важнейшие клетки человеческого организма – B-лимфоциты. Они являются важной составляющей иммунной системы. Возбудитель, попадая в детский организм, ослабляет иммунную систему. Следствием этого является повышение восприимчивости ребенка к другим инфекциям. При обнаружении признаков ангины и гриппа стоит посетить врача, так как это могут быть симптомы инфекционного мононуклеоза.
В качестве примера можно привести следующую ситуацию. В организм ребенка попадает вирус Эпштейна-Барра и вызывает ангину. Малыш переносит ее. Затем у него через короткий промежуток времени после выздоровления снова возникает ангина. На этот раз ее вызвал стрептококк. Также мононуклеоз может вызвать такие осложнения, как гнойный отит (воспаление среднего уха), бронхит, воспаление легких.
Диагностика мононуклеоза
При первом посещении медицинского учреждения врач проводит осмотр, выясняет симптомы. При подозрении на инфекционный мононуклеоз сдается анализ крови. Он необходим не только для подтверждения данного заболевания, но и для исключения иных проблем со здоровьем. Если в крови выявляют атипичные мононуклеары, то это подтверждает диагноз «мононуклеоз». Чем больше подобных клеток обнаруживается в крови, тем тяжелее будет протекать заболевание.
При подозрении на мононуклеоз может быть проведена полимеразная цепная реакция. Благодаря этому современному методу исследования в крови можно обнаружить генетический материал самого вируса.
Больных людей с подозрением на мононуклеоз обследуют на ВИЧ-инфекцию, на ранних стадиях которой могут быть мононуклеозо-подобные симптомы. Также проводится бактериологическое исследование с целью исключить наличие дифтерии у пациента.
Лечение мононуклеоза
Лечение больных людей, страдающих данным заболеванием в легкой форме, может осуществляться на дому. Детей с тяжелыми формами мононуклеоза при значительном увеличении селезенки и печени, возникновении желтухи госпитализируют в инфекционный стационар.
Для лечения инфекционного мононуклеоза не создано специальных препаратов. Врачи назначают лекарственные средства, которые облегчают симптомы и предупреждают возникновение осложнений. Больной человек должен больше времени проводить в состоянии покоя. Постельный режим необходимо соблюдать в течение 1-3 недель. Физическая нагрузка должна быть исключена, так как есть риск разрыва селезенки.
Снижать температуру с помощью аспирина нельзя. Этот препарат может стать причиной возникновения осложнений. Например, аспирин провоцирует возникновение острой печеночной энцефалопатии (синдрома Рея). Это состояние очень опасно для человека, так как оно характеризуется нарушением функции головного мозга, развитием жировой инфильтрации печени. Нельзя использовать и парацетамол. Данное лекарственное средство перегружает печень.
При мононуклеозе можно закапывать сосудосуживающие препараты в нос. Они облегчают дыхание. В целях профилактики ангины, фарингита необходимо полоскание глотки и зева настойками шалфея, ромашки, календулы. Эти средства можно применять для лечения инфекционного мононуклеоза у детей.
Проводится антибактериальная терапия с учетом чувствительности микрофлоры. Лекарственные препараты из группы аминопенициллинов (например, амоксициллин, ампициллин) не рекомендуется применять из-за частого возникновения побочных реакций. Людям с тяжелой формой инфекционного мононуклеоза назначают глюкокортикоиды (дексаметазон, преднизолон).
Мононуклеоз у взрослых и детей протекает тяжело, но выздоровление наступает. После этого иммунная система еще очень долго не может восстановиться. Нарушения в ней могут сохраняться в течение 6 месяцев. Дети после выздоровления очень восприимчивы к различным инфекциям. Родителям стоит ограничивать контакты своих чад с другими малышами, а поездки и прививки рекомендуется перенести на более поздний срок.
Поделиться «Инфекционный мононуклеоз — симптомы, лечение, причины»
nardar.ru
Инфекционный мононуклеоз — симптомы болезни, профилактика и лечение Инфекционного мононуклеоза, причины заболевания и его диагностика на EUROLAB
Что такое Инфекционный мононуклеоз —
Инфекционный мононуклеоз (mononucleosis infectiosa, болезнь Филатова, ангина моноцитарная, лимфобластоз доброкачественный) — острое антропонозное вирусное инфекционное заболевание с лихорадкой, поражением ротоглотки, лимфатических узлов, печени и селезёнки и специфическими изменениями гемограммы.Клинические проявления заболевания впервые описаны Н.Ф. Филатовым («болезнь Филатова», 1885) и Е. Пфайффером (1889). Изменения гемограммы изучены многими исследователями (Берне Й., 1909; Тайди Г. с соавт., 1923; Шварц Е., 1929, и др.). В соответствии с этими характерными изменениями американские учёные Т. Спрэнт и Ф. Эванс назвали заболевание инфекционным мононуклеозом. Возбудитель впервые выделили английский патолог М.А. Эпстайн и канадский вирусолог И. Барр из клеток лимфомы Бёркитта (1964). Позднее вирус получил название вируса Эпстайна-Барр.
Что провоцирует / Причины Инфекционного мононуклеоза:
Возбудитель инфекционного мононуклеоза— ДНК-геномный вирус рода Lymphocryptovirus подсемейства Gammaherpesvirinae семейства Herpesviridae. Вирус способен реплицироваться, в том числе в В-лимфоцитах; в отличие от других вирусов герпеса он не вызывает гибели клеток, а напротив, активирует их пролиферацию. Вирионы включают специфические антигены: капсидный (VCA), ядерный (EBNA), ранний (ЕА) и мембранный (МА) антигены. Каждый из них образуется в определённой последовательности и индуцирует синтез соответствующих антител. В крови больных инфекционным мононуклеозом сначала появляются антитела к капсидному антигену, позднее вырабатываются антитела к ЕА и МА. Возбудитель малоустойчив во внешней среде и быстро гибнет при высыхании, под действием высокой температуры и дезинфектантов.Инфекционный мононуклеоз — только одна из форм инфекции вирусом Эпстайна-Барр, который также вызывает лимфому Бёркитта и носоглоточную карциному. Его роль в патогенезе ряда других патологических состояний недостаточно изучена.
Резервуар и источник инфекции — человек с манифестной или стёртой формой болезни, а также носитель возбудителя. Инфицированные лица выделяют вирус с последних дней инкубации и на протяжении 6-18 мес после первичной инфекции. В смывах из ротоглотки у 15-25% серопозитивных здоровых людей также обнаруживают вирус. Эпидемический процесс поддерживают лица, ранее перенёсшие инфекцию и на протяжении долгого времени выделяющие возбудитель со слюной.
Механизм передачи — аэрозольный, путь передачи — воздушно-капельный. Очень часто вирус выделяется со слюной, поэтому возможно заражение контактным путём (при поцелуях, половым путём, через руки, игрушки и предметы обихода). Возможна передача инфекции при переливаниях крови, а также во время родов.
Естественная восприимчивость людей высокая, однако, преобладают лёгкие и стёртые формы болезни. О наличии врождённого пассивного иммунитета может свидетельствовать крайне низкая заболеваемость детей первого года жизни. Иммунодефицитные состояния способствуют генерализации инфекции.
Основные эпидемиологические признаки. Заболевание распространено повсеместно; в основном регистрируют спорадические случаи, иногда — небольшие вспышки. Полиморфность клинической картины, довольно частые сложности диагностики болезни дают основания полагать, что уровень официально регистрируемой заболеваемости в Украине не отражает истинной широты распространения инфекции. Наиболее часто заболевают подростки, у девочек максимальную заболеваемость регистрируют в 14-16 лет, у мальчиков — в 16-18 лет. Поэтому иногда инфекционный мононуклеоз также называют болезнью «студентов». Лица старше 40 лет болеют редко, но у ВИЧ-инфицированных реактивация латентной инфекции возможна в любом возрасте. При заражении в раннем детском возрасте первичная инфекция протекает в виде респираторного заболевания, в более старших возрастах — бессимптомно. К 30-35 годам у большинства людей в крови выявляют антитела к вирусу инфекционного мононуклеоза, поэтому клинически выраженные формы редко встречают среди взрослых. Заболевания регистрируют на протяжении всего года, несколько реже — в летние месяцы. Заражению способствуют скученность, пользование общим бельём, посудой, тесные бытовые контакты.
Патогенез (что происходит?) во время Инфекционного мононуклеоза:
Проникновение вируса в верхние отделы дыхательных путей приводит к поражению эпителия и лимфоидной ткани рото- и носоглотки. Отмечают отёк слизистой оболочки, увеличение миндалин и регионарных лимфатических узлов. При последующей вирусемии возбудитель внедряется в В-лимфоциты; находясь в их цитоплазме, он диссеминирует по всему организму. Распространение вируса приводит к системной гиперплазии лимфоидной и ретикулярной тканей, в связи с чем в периферической крови появляются атипичные мононуклеары. Развиваются лимфаденопатия, отёк слизистой оболочки носовых раковин и ротоглотки, увеличиваются печень и селезёнка. Гистологически выявляют гиперплазию лимфоретикулярной ткани во всех органах, лимфоцитарную перипортальную инфильтрацию печени с незначительными дистрофическими изменениями гепатоцитов.Репликация вируса в В-лимфоцитах стимулирует их активную пролиферацию и дифференцировку в плазмоциты. Последние секретируют иммуноглобулины низкой специфичности. Одновременно в острый период заболевания нарастают количество и активность Т-лимфоцитов. Т-супрессоры сдерживают пролиферацию и дифференцировку В-лимфоцитов. Цитотоксические Т-лимфоциты уничтожают инфицированные вирусом клетки, распознавая мембранные вирус-индуцированные антигены. Однако вирус остаётся в организме и персистирует в нём в течение всей последующей жизни, обусловливая хроническое течение заболевания с реактивацией инфекции при снижении иммунитета.
Выраженность иммунологических реакций при инфекционном мононуклеозе позволяет считать его болезнью иммунной системы, поэтому его относят к группе заболеваний СПИД-ассоциированного комплекса.
Симптомы Инфекционного мононуклеоза:
Инкубационный период варьирует от 5 дней до 1,5 мес. Возможен продромальный период, не имеющий специфической симптоматики. В этих случаях заболевание развивается постепенно: в течение нескольких дней наблюдают субфебрильную температуру тела, недомогание, слабость, повышенную утомляемость, катаральные явления в верхних дыхательных путях — заложенность носа, гиперемию слизистой оболочки ротоглотки, увеличение и гиперемию миндалин.При остром начале заболевания температура тела быстро поднимается до высоких цифр. Больные жалуются на головную боль, боли в горле при глотании, озноб, усиленное потоотделение, ломоту в теле. В дальнейшем температурная кривая может быть различной; длительность лихорадки варьирует от нескольких дней до 1 мес и более.
К концу первой недели заболевания развивается период разгара болезни. Характерно появление всех основных клинических синдромов: общетоксических явлений, ангины, лимфаденопатии, гепатолиенального синдрома. Самочувствие больного ухудшается, отмечают высокую температуру тела, озноб, головную боль и ломоту в теле. Могут появиться заложенность носа с затруднением носового дыхания, гнусавость голоса. Поражения зева проявляются нарастанием боли в горле, развитием ангины в катаральной, язвенно-некротической, фолликулярной или плёнчатой форме. Гиперемия слизистой оболочки выражена нерезко, на миндалинах появляются рыхлые желтоватые легко снимающиеся налёты. В некоторых случаях налёты могут напоминать дифтерийные. На слизистой оболочке мягкого нёба возможно появление геморрагических элементов, задняя стенка глотки резко гиперемированная, разрыхлённая, зернистая, с гиперплазированными фолликулами.
С первых же дней развивается лимфаденопатия. Увеличенные лимфатические узлы можно обнаружить во всех доступных пальпации областях; характерна симметричность их поражения. Наиболее часто при мононуклеозе увеличиваются затылочные, подчелюстные и особенно заднешейные лимфатические узлы с обеих сторон по ходу грудино-ключично-сосцевидных мышц. Лимфатические узлы уплотнены, подвижны, при пальпации безболезненны или болезненны незначительно. Их размеры варьируют от горошины до грецкого ореха. Подкожная клетчатка вокруг лимфатических узлов в некоторых случаях может быть отёчной.
У большинства больных в период разгара заболевания отмечают увеличение печени и селезёнки. В некоторых случаях развивается желтушный синдром: усиливаются диспептические явления (снижение аппетита, тошнота), темнеет моча, появляется иктеричность склер и кожи, в сыворотке крови нарастает содержание билирубина и повышается активность аминотрансфераз.
Иногда появляется экзантема пятнисто-папулёзного характера. Она не имеет определённой локализации, не сопровождается зудом и быстро исчезает без лечения, не оставляя изменений на коже.
Вслед за периодом разгара заболевания, продолжающимся в среднем 2-3 нед, наступает период реконвалесценции. Самочувствие больного улучшается, нормализуется температура тела, постепенно исчезают ангина и гепатолиенальный синдром. В дальнейшем нормализуются размеры лимфатических узлов. Длительность периода реконвалесценции индивидуальна, иногда субфебрильная температура тела и лимфаденопатия сохраняются в течение нескольких недель.
Заболевание может протекать длительно, со сменой периодов обострений и ремиссий, из-за чего его общая продолжительность может затягиваться до 1,5 лет.
Клинические проявления инфекционного мононуклеоза у взрослых больных отличаются рядом особенностей. Заболевание часто начинается с постепенного развития продромальных явлений, лихорадка часто сохранятся более 2 нед, выраженность лимфаденопатии и гиперплазии миндалин меньше, чем у детей. Вместе с тем у взрослых чаще наблюдают проявления заболевания, связанные с вовлечением в процесс печени и развитием желтушного синдрома.
Осложнения инфекционного мононуклеоза
Наиболее частое осложнение — присоединение бактериальных инфекций, вызванных золотистым стафилококком, стрептококками и др. Также возможны менингоэнцефалит, обструкция верхних отделов респираторного тракта увеличенными миндалинами. В редких случаях отмечают двустороннюю интерстициальную инфильтрацию лёгких с тяжёлой гипоксией, тяжёлый гепатит (у детей), тромбоцитопению, разрывы селезёнки. В большинстве случаев прогноз заболевания благоприятный.
Диагностика Инфекционного мононуклеоза:
Инфекционный мононуклеоз следует отличать от лимфогранулематоза и лимфолейкоза, ангин кокковой и иной этиологии, дифтерии ротоглотки, а также вирусных гепатитов, псевдотуберкулёза, краснухи, токсоплазмоза, хламидийных пневмоний и орни-тоза, некоторых форм аденовирусной инфекции, ЦМВ-инфекции, первичных проявлений ВИЧ-инфекции. Инфекционный мононуклеоз отличает сочетание основных пяти клинических синдромов: общетоксических явлений, двусторонней ангины, полиаденопатии (особенно с поражением лимфатических узлов по ходу грудино-ключично-сосцевидных мышц с обеих сторон), гепатолиенального синдрома, специфических изменений гемограммы. В некоторых случаях возможны желтуха и (или) экзантема пятнисто-папулёзного характера.Лабораторная диагностика инфекционного мононуклеоза
Наиболее характерный признак — изменения клеточного состава крови. В гемограмме выявляют умеренный лейкоцитоз, относительную нейтропению со сдвигом лейкоцитарной формулы влево, значительное увеличение количества лимфоцитов и моноцитов (суммарно более 60%). В крови присутствуют атипичные мононуклеары — клетки с широкой базофильной цитоплазмой, имеющие различную форму. Их наличие в крови определило современное название болезни. Диагностическое значение имеет увеличение количества атипичных мононуклеаров с широкой цитоплазмой не менее чем до 10-12%, хотя число этих клеток может достигать 80-90%. Следует заметить, что отсутствие атипичных мононуклеаров при характерных клинических проявлениях заболевания не противоречит предполагаемому диагнозу, поскольку их появление в периферической крови может задерживаться до конца 2-3-й недели болезни.
В период реконвалесценции количество нейтрофилов, лимфоцитов и моноцитов постепенно нормализуется, однако довольно часто длительно сохраняются атипичные мононуклеары.
Вирусологические методы диагностики (выделение вируса из ротоглотки) на практике не применяют. Методом ПЦР можно выявлять вирусную ДНК в цельной крови и сыворотке.
Разработаны серологические методы определения антител различных классов к капсидным (VCA) антигенам. Сывороточные IgM к VCA-антигенам можно обнаружить уже в инкубационный период; в дальнейшем их выявляют у всех больных (это служит достоверным подтверждением диагноза). Исчезают IgM к VCA-антигенам лишь через 2-3 мес после выздоровления. После перенесённого заболевания пожизненно сохраняются IgG к VCA-антигенам.
При отсутствии возможности определения анти-VCA-IgM до сих пор применяют серологические методы обнаружения гетерофильных антител. Они образуются в результате поликлональной активации В-лимфоцитов. Наиболее популярны реакция Пауля-Буннеля с эритроцитами барана (диагностический титр 1:32) и более чувствительная реакция Гоффа-Бауэра с эритроцитами лошади. Недостаточная специфичность реакций снижает их диагностическую ценность.
Всем больным с инфекционным мононуклеозом или при подозрении на него нужно проводить 3-кратное (в острый период, затем через 3 и 6 мес) лабораторное обследование на антител к антигенам ВИЧ, поскольку в стадию первичных проявлений ВИЧ-инфекции также возможен мононуклеозоподобный синдром.
Лечение Инфекционного мононуклеоза:
Больных лёгкими и среднетяжёлыми формами инфекционного мононуклеоза можно лечить на дому. Необходимость постельного режима определяется выраженностью интоксикации. В случаях заболевания с проявлениями гепатита рекомендуют диету (стол №5).Специфическая терапия не разработана. Проводят дезинтоксикационную терапию, десенсибилизирующее, симптоматическое и общеукрепляющее лечение, полоскания ротоглотки растворами антисептиков. Антибиотики при отсутствии бактериальных осложнений не назначают. При гипертоксическом течении заболевания, а также при угрозе асфиксии, обусловленной отёком глотки и выраженным увеличением миндалин, назначают короткий курс лечения глюкокортикоидами (преднизолон внутрь в суточной дозе 1-1,5 мг/кг в течение 3-4 дней).
Профилактика Инфекционного мононуклеоза:
Общие меры профилактики аналогичны таковым при ОРВИ. Меры специфической профилактики не разработаны. Неспецифическую профилактику осуществляют повышением общей и иммунологической резистентности организма.
К каким докторам следует обращаться если у Вас Инфекционный мононуклеоз:
Вас что-то беспокоит? Вы хотите узнать более детальную информацию о Инфекционного мононуклеоза, ее причинах, симптомах, методах лечения и профилактики, ходе течения болезни и соблюдении диеты после нее? Или же Вам необходим осмотр? Вы можете записаться на прием к доктору – клиника Eurolab всегда к Вашим услугам! Лучшие врачи осмотрят Вас, изучат внешние признаки и помогут определить болезнь по симптомам, проконсультируют Вас и окажут необходимую помощь и поставят диагноз. Вы также можете вызвать врача на дом. Клиника Eurolab открыта для Вас круглосуточно.
Как обратиться в клинику:
Телефон нашей клиники в Киеве: (+38 044) 206-20-00 (многоканальный). Секретарь клиники подберет Вам удобный день и час визита к врачу. Наши координаты и схема проезда указаны здесь. Посмотрите детальнее о всех услугах клиники на ее персональной странице.
Если Вами ранее были выполнены какие-либо исследования, обязательно возьмите их результаты на консультацию к врачу. Если исследования выполнены не были, мы сделаем все необходимое в нашей клинике или у наших коллег в других клиниках.
У Вас ? Необходимо очень тщательно подходить к состоянию Вашего здоровья в целом. Люди уделяют недостаточно внимания симптомам заболеваний и не осознают, что эти болезни могут быть жизненно опасными. Есть много болезней, которые по началу никак не проявляют себя в нашем организме, но в итоге оказывается, что, к сожалению, их уже лечить слишком поздно. Каждое заболевание имеет свои определенные признаки, характерные внешние проявления – так называемые симптомы болезни. Определение симптомов – первый шаг в диагностике заболеваний в целом. Для этого просто необходимо по несколько раз в год проходить обследование у врача, чтобы не только предотвратить страшную болезнь, но и поддерживать здоровый дух в теле и организме в целом.
Если Вы хотите задать вопрос врачу – воспользуйтесь разделом онлайн консультации, возможно Вы найдете там ответы на свои вопросы и прочитаете советы по уходу за собой. Если Вас интересуют отзывы о клиниках и врачах – попробуйте найти нужную Вам информацию в разделе Вся медицина. Также зарегистрируйтесь на медицинском портале Eurolab, чтобы быть постоянно в курсе последних новостей и обновлений информации на сайте, которые будут автоматически высылаться Вам на почту.
Другие заболевания из группы Инфекционные и паразитарные болезни:
Если Вас интересуют еще какие-нибудь виды болезней и группы заболеваний человека или у Вас есть какие-либо другие вопросы и предложения – напишите нам, мы обязательно постараемся Вам помочь.www.eurolab-portal.ru
Мононуклеоз. Что это такое и насколько опасно заболевание?
Вирусное острое заболевание, сопровождающееся поражением ротовой полости, горла, лихорадкой, затрагивающее лимфатические узлы, а нередко печень и селезенку, называют мононуклеозом. Что это такое и чем оно вызвано?
Обыкновенная ангина — наиболее часто именно с ней путают мононуклеоз. Что это такое — одно и то же или лишь заболевания со схожими симптомами? Как можно различить данные болезни? Их схожесть проявляется всегда в общих реакциях организма человека: повышается температура, возникает лихорадка и другие признаки. Ведь инфекционные заболевания — это болезни, вызываемые и поддерживаемые присутствием в организме возбудителя — чужеродного агента. Они очень динамичны, симптоматическая картина может быстро меняться. Поэтому для того, чтобы отличить мононуклеоз от ангины, важно установить верный диагноз, пройти все необходимые исследования, что позволит выбрать грамотный алгоритм лечения. Ангина может протекать как самостоятельное заболевание или быть проявлением другого недуга. Инфекционный мононуклеоз характеризуется не только воспалительным процессом в горле, но и значительным увеличением лимфатических узлов, печени, селезенки, выраженными изменениями лейкоцитарной формулы крови.

Несвоевременное выявление и неграмотное лечение могут привести к серьезным осложнениям, поэтому при подозрении на мононуклеоз обязательно проводится моноспот-тест для выявления основного возбудителя. Данное исследование крови позволяет исключить другие болезни, схожие с мононуклеозом по симптомам (лимфолейкоз, дифтерию ротоглотки, псевдотуберкулез, вирусные гепатиты, хламидийную пневмонию, краснуху, токсоплазмоз, аденовирусную инфекцию).
Единой классификации форм клинического проявления инфекционного мононуклеоза нет. Но следует знать, что помимо типичных форм заболевания, могут проявляться и атипичные. Для последних может быть характерно отсутствие одного из основных симптомов болезни (лимфаденопатии, тонзиллита, увеличения печени и селезенки), преобладание и выраженность одного из ее проявлений (некротический тонзиллит, экзантема), возникновение необычных симптомов (появление желтухи) или иных проявлений, которые относят к осложнениям.

Схожесть со всевозможными инфекционными заболеваниями сильно затрудняет постановку верного диагноза. Опасность хронического мононуклеоза заключается в сильно ослабленном иммунитете, поскольку повышается риск появления других инфекций, различных осложнений (отек слизистой глотки, разрыв селезенки и иных). При данной форме заболевания необходимо наиболее четко определить критерии, дающие возможность выявить мононуклеоз и провести правильный курс лечения.
Следует отметить, что наблюдается высокая устойчивость антител у людей, перенесших мононуклеоз. Что это такое и как он выражается? У большинства переболевших вырабатывается к вирусу иммунитет. Но тот продолжает оставаться в организме человека, способен периодически активизироваться и передаваться другим людям.
fb.ru